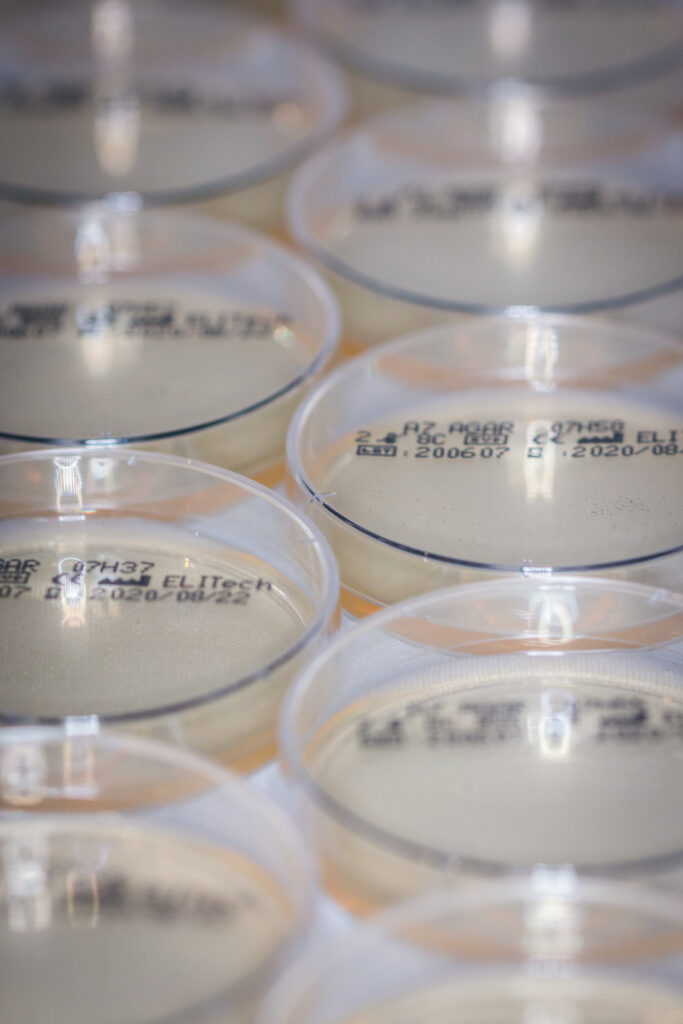

Choose your sales office
About Microbiology
ELITechGroup Microbiology relies on its strong credo: to provide reliable and simple diagnostic tools for proximity labs in the Biology area. Our innovative products are derived from our wide expertise combining agglutination tests, identification trays for identification or susceptibility testing. We bring our diagnostic support in the fields of Bacteriology, Mycology and Parasitology.
Latest news
NEWSROOM
Let us help you
For general inquiries, please use the links to the right. Click Contact to complete a brief online form, or click Support for general phone and email information. Someone will be in touch with you soon.

